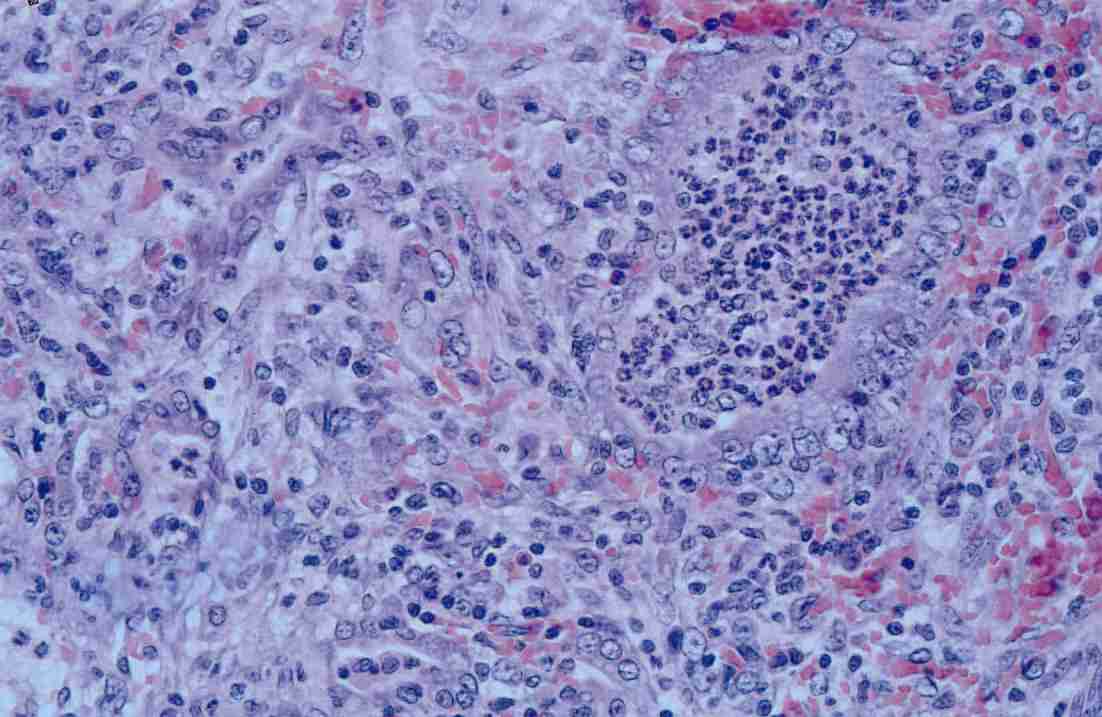
p>仙台病毒亦称hvj(hemagglutinating virus of japan的缩写),乙型副

小鼠仙台病毒

八年级生物下册_第一节传染病及其预防课件_人教新课标版ppt
图片尺寸1080x810
鼠疫可防可治面对鼠疫我们可以做什么
图片尺寸740x492
p>仙台病毒亦称hvj(hemagglutinating virus of japan的缩写),乙型副
图片尺寸336x354
congos ebola outbreak reports 1st confirmed urban case
图片尺寸1024x798
病毒也有"免疫系统"
图片尺寸528x527
小鼠(mouse)仙台病毒抗体(sev-ab) elisa检测试剂盒
图片尺寸800x800
基因进化双面性:成也萧何,败也萧何!_盛景基因
图片尺寸600x315
鼠疫和新冠肺炎哪个更可怕?由宁夏鼠疫患者来谈谈鼠疫那些事儿
图片尺寸1200x801
researchers confirm black death killer bacteria
图片尺寸2092x1512
影响全球的十大病毒:鼠疫(一)
图片尺寸864x486
诱导动物细胞融合的方法
图片尺寸600x427
大连寻梦农资商城,农资批发,技术服务,买正品农资到寻梦农资商城
图片尺寸640x480
鼠疫史上最可怕的瘟疫
图片尺寸1280x835
p>仙台病毒亦称hvj(hemagglutinating virus of japan的缩写),乙型副
图片尺寸1102x717
预防鼠疫,人人有责—勐腊县勐哈幼儿园鼠疫防控宣传
图片尺寸828x588
可能喜欢 常见细菌性传染病 非传染性病害 细菌性角斑病 病毒性传染病
图片尺寸1080x810
大连寻梦农资商城,农资批发,技术服务,买正品农资到寻梦农资商城
图片尺寸640x480
银川确诊一例输入性鼠疫病例以目前的科技水平鼠疫还有威胁吗
图片尺寸1000x750
鼠疫病毒
图片尺寸500x408
「周知」鼠疫可防可治,面对鼠疫我们可以做什么?
图片尺寸640x506